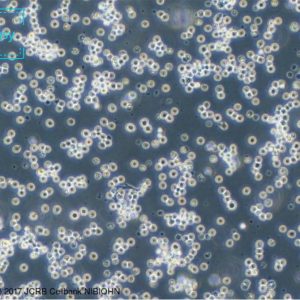
人Burkitt's淋巴瘤细胞

-

人前列腺癌细胞
Lncap -

人神经母细胞瘤细胞
SH-SY5Y -

人胚肺成纤维细胞
MRC-5 -

卵巢腺癌细胞
CAOV-3 -

小鼠胰岛β细胞系
Min6 -

小鼠脑微血管内皮细胞系
Bend.3 -
人Burkitt’s淋巴瘤细胞
Daudi -

人T淋巴细胞白血病细胞
Jurkat -

人前列腺癌细胞
PC3 -

人单核细胞白血病细胞
THP-1 -

人原髓细胞白血病细胞
HL-60 -

人宫颈癌细胞
Hela -

人正常肝细胞
L-O2 -

人永生化角质细胞
HaCat -

人纤维肉瘤细胞
HT-1080 -

人组织细胞淋巴瘤细胞
U-937 -

人结直肠腺癌细胞
HT-29 -

人结肠癌细胞
HCT116 -

人肝癌细胞
Hep3B2.1-7 -

人肾皮质近曲小管上皮细胞
HK-2 -

人肾细胞腺癌细胞
786-O -

人胃黏膜细胞
GES-1 -

人胰腺癌细胞
PANC-1 -

人脐静脉内皮细胞
HUVEC -

人脐静脉细胞融合细胞
EA.HY926 -

人脑星形胶质母细胞瘤
U87MG -

人舌鳞癌细胞
Cal-27 -

大鼠胰岛细胞瘤细胞
INS-1 -

小鼠T淋巴细胞
CTLL-2 -

小鼠海马神经元细胞
HT22 -

小鼠胚胎成纤维细胞
NIH/3T3 -

小鼠胚胎成骨细胞前体细胞
MC3T3-E1 -

犬肾细胞
MDCK -

非洲绿猴肾细胞
Vero -

人心肌细胞
AC16 -

人胃腺癌细胞
AGS -

人胎盘绒膜癌细胞
Bewo -

人非小细胞肺癌细胞
A549 -

人骨肉瘤细胞
143B -

人鼻咽癌细胞
C666-1 -

仓鼠肾成纤维细胞
BHK-21 -

小鼠B细胞淋巴瘤细胞
A20 -

小鼠乳腺癌细胞
4T1 -

小鼠原B细胞株
BaF3 -

小鼠结肠癌细胞
CT26 -

小鼠胚胎成纤维细胞
3T3-L1 -

小鼠黑色素瘤细胞
B16-F10 -

人乳腺癌细胞
MCF-7 -

人卵巢颗粒细胞瘤细胞
KGN -

人支气管上皮细胞
BEAS-2B -

人结肠腺癌细胞
Caco-2 -

人肝癌细胞
HuH-7 -

人肝癌细胞
HEPG2 -

人肺癌细胞
PC-9 -

人胚肾细胞
293T -

人软骨细胞永生化
Immortalized Human Chondrocytes -

仓鼠卵巢细胞
CHO -

大鼠心肌细胞
H9C2 -

小鼠Lewis肺癌细胞
LLC -

小鼠单核巨噬细胞白血病细胞
RAW 264.7 -

小鼠小胶质细胞
BV2 -

小鼠成纤维细胞
L-929 -

小鼠成肌细胞
C2C12 -

小鼠结肠癌细胞
MC38 -

小鼠肝癌细胞
HEPA1-6 -

小鼠肺腺癌细胞
LA795 -

猫肾细胞
F81

